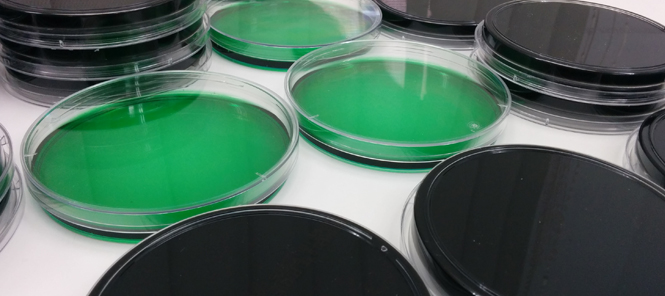

- Inicio
- Actualidad
- Empresa
- Servicios
- AREA AGROALIMENTARIA
- AREA MEDIOAMBIENTAL
- Cursos
- ASESORÍA / CONSULTORÍA
- Documentación
- Certificados
- Enlaces
- Contacto
974 22 54 00 cobrial@laboratorioscobrial.es

Dedicada a la asesoría de calidad y seguridad alimentarias en cualesquiera de las fases de las industria agroalimentaria.

2020-04-14

2020-04-14

2019-03-12
AREA AGROALIMENTARIA
AREA MEDIOAMBIENTAL
CURSOS
ASESORÍA / CONSULTORÍA
COBRIAL LABORATORIOS
P. Extremadura 4 Bis 22004 Huesca Tlf. y Fax. 974 22 54 00 cobrial@laboratorioscobrial.es